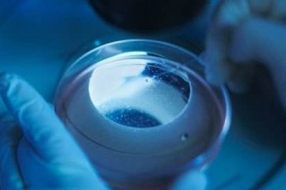
如何设置正确的数据备份策略?

保护数据免受损坏、灾难(人为或自然)和其他问题的影响是IT部门的首要任务之一。从概念上讲,这些想法很简单,但实现有效的数据备份可能是一件很困难的事。
在过去几十年里,备份可以说已经成为数据保护的同义词,行业内有几种常见的方法。备份软件应用程序降低了执行备份与恢复操作的复杂性。值得一提的是,备份数据只是灾难保护计划的一部分,如果没有认真的设计和测试,可能无法提供所需的数据备份和灾难恢复能力。
不同的备份应用程序一般会提供几种类型的备份方式:最常见的是完全备份、增量备份和差异备份。其他还有合成完全备份和镜像等。
对于云备份和本地备份而言,不同的备份类型适合不同的环境。如果您采用的是云备份,增量备份一般会更加适合,因为增量备份消耗的资源更少。您可以从云中的完全备份开始,然后转向增量备份。镜像备份通常是一种本地备份方法,往往保存在本地磁盘中。
完全备份
最基本和最完整的备份操作类型就是完全备份。顾名思义,这种类型的备份会将所有数据复制到另一组存储媒介中,如磁盘或磁带。采用完全备份的主要优点是,所有数据的完全副本都保存在一组存储媒介中。这样恢复数据的时间最短,可以提供更好的RTO(恢复时间目标)。其缺点是执行完全备份所需的时间比其他类型长(有时是10倍或更多),并且需要更多的存储空间。
因此,完全备份通常只是每隔一段时间定期执行。拥有少量数据(或关键应用程序)的数据中心可能会选择每天都执行完全备份,在某些情况下甚至更频繁。通常,系统备份策略需要将完全备份与增量备份或差异备份相结合。
增量备份
增量备份是指在一次全备份或上一次增量备份后,以后每次的备份只需备份与前一次相比增加或者被修改的文件。通常会对文件使用修改后的时间戳,并将其与上次备份的时间戳进行比较。备份应用程序跟踪并记录备份操作发生的日期和时间,以便跟踪自这些操作以来修改的文件。
因为增量备份只会复制最后一次备份以来的数据,所以企业可以根据需要经常执行,只保存最近的更改。增量备份的好处是,它复制的数据量比完全备份少。因此,这些操作能够更快地完成,并且需要更少的介质来存储备份。
差异备份
差异备份操作类似于增量备份执行的第一次操作,因为它将复制前一次备份中更改的所有数据。但是,每次运行之后,它都会继续复制上次完全备份之后更改的所有数据。因此,后续操作中它会比增量备份存储更多的数据,当然一般也远远少于完全备份。此外,与增量备份相比,差异备份需要更多的空间和时间来完成,不过比完全备份要少。
每个进程的工作方式不同,不过组织必须至少运行一次完全备份。之后,可以运行另一个完全备份、增量备份或差异备份。执行的第一个部分备份(差异备份或增量备份)将备份相同的数据。到第三次备份操作时,增量备份的数据仅限于自上次增量备份以来的更改。相比之下,差异备份将保存自第一个完全备份(即“backup 1”)以来的所有更改。
从这三种主要的备份类型中,可以开发出一种全面保护数据的方法。组织经常使用以下方法之一:
·每天完全备份
·每周完全备份+每天差异备份
·每周完全备份+每天增量备份
在制定合理的备份策略是,会受到许多因素的影响。通常,每个备选方案和策略的选择,都要在性能、数据保护级别、保留的数据总量和成本之间进行权衡。
每天执行完全的备份需要最多的空间,也将花费最多的时间。但是可以使用更多的数据副本,并且执行恢复操作所需的媒介更少。因此,实现这种备份策略具有更高的灾难容忍度,并且提供了最少的恢复时间,因为所需的任何数据块都将位于最多一个备份集群中。
作为一种替代方案,每周执行一次完全备份,再加上每天执行增量备份,将在工作日提供最短的备份时间,并使用最少的存储空间。但是,可用的数据副本较少,恢复时间最长,因为组织可能需要使用好几组媒介来恢复必要的信息。如果需要从周三备份的数据中获取数据,则需要周日的完全备份,以及周一、周二和周三的增量媒介集。这可以显着增加恢复时间,并需要每个媒介集正常工作,一个备份集中的失败会影响整个恢复。
每周运行一次完全备份,加每天运行一次差异备份属于一种比较中和的方案。也就是说,与使用每日完全备份策略相比,恢复需要更多的备份媒介集,但比使用每日增量备份策略要少。此外,恢复时间比使用每日增量备份要短,而比使用每日完全备份要长。为了恢复某一天的数据,最多需要两个媒介集,这减少了恢复所需的时间和不可读备份集可能出现的问题。
镜像备份
镜像备份相当于完全备份。这种备份类型创建源数据集的精确副本,但是只有最新的数据版本存储在备份存储库中,不跟踪不同版本的文件。备份是源数据的镜像,因此得名。所有不同的备份文件都是单独存储的,就像源数据中一样。
镜像备份的好处之一是快速恢复时间。访问单独备份的文件也很容易。
不过,主要缺点之一是需要大量的存储空间。有了这些额外的存储,组织应该留意成本的增加和维护需求。此外,如果源数据集中有问题,比如损坏或删除,镜像备份也会遇到同样的问题。因此,最好不要太依赖于镜像备份来满足所有数据保护需求,而应该为数据提供其他类型的备份。您可以参考3-2-1备份原则,包括在两种不同媒介上复制三份数据,在站点外复制一份。
磁盘镜像是一种特殊的镜像,也称为RAID 1。这个过程将数据复制到两个或多个磁盘。对于需要高可用性的数据,磁盘镜像是一个非常不错的选择,因为它具有快速的恢复时间。它还有助于灾难恢复,因为它具有即时故障转移功能。磁盘镜像至少需要两个物理驱动器。如果一个驱动器发生故障,组织可以使用镜像副本。虽然磁盘镜像提供了全面的数据保护,但它需要较大的存储容量。
制定合适的策略
对于拥有小数据集的组织,每天运行完全备份可以提供高级别的保护,而不需要额外的存储空间成本。对于较大的组织或拥有更多数据或服务器卷的组织来说,每周执行一次完全备份,加上每天一次的增量备份或差异备份,会是更好的选择。使用差异备份提供了更高级别的数据保护,在大多数情况下,恢复时间更短,存储容量也略有增加。因此,对于许多组织来说,使用每周完全备份和每日差异备份的策略是一个不错的选择。
大多数高级备份类型(如合成全备份、镜像备份和连续数据保护)都需要将磁盘存储作为备份目标。合成全备份可以使用所有需要的增量备份或磁盘上的差异备份来重建完全的备份映像。然后,可以将这个合成全备份数据存储到磁带上进行异地存储,其优点是减少了恢复时间。最后,与传统备份选项相比,连续数据保护支持更多的恢复点。
在决定使用哪种类型的备份策略时,关键在于何时使用哪种策略,以及如何将这些选项与测试结合起来,以满足总体业务成本、性能和可用性目标。
大多数备份的目的是创建数据的副本,以便在数据丢失、损坏或删除或灾难发生后恢复特定的文件或应用程序。因此,备份不是目标,而是实现数据保护目标的一种手段。对备份进行测试,与备份和恢复数据一样重要。同样,备份数据的目的是在之后的时间点恢复数据。没有定期的测试,就不可能保证达到保护数据的目标。